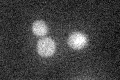
YOL078W
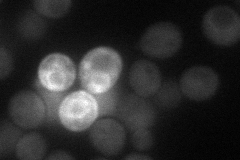
YOL078W
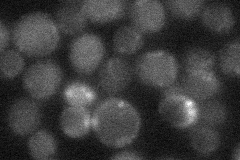
YOL078W
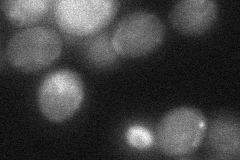
YOL078W
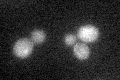
YOL078W

View description
Component of a membrane-bound complex containing the Tor2p kinase and other proteins, which may have a role in regulation of cell growth
Localization:
Intensity:
Fold change:
Significance:
-
C’ GFP library in SD
below threshold20.25 -
N' NOP1pr-GFP in SD
cytosol33.2208 -
N' TEF2pr-mCherry in SD

cytosol32.3675 -
N' NATIVEpr-GFP in SD
below threshold18.6493 -
N' TEF2pr-VC and Cyto-VN in SD
cytosol29.7426 -
C’ GFP library in SD+DTT
cytosol17.360.85No -
C’ GFP library in SD+H2O2

cytosol22.741.12No -
C’ GFP library in Starvation Media

cytosol18.020.88No -
C’ GFP library on the background of Pup2-DaMP

below threshold -
C’ GFP library on the background of CCT mutant

below threshold34.79941.7174Yes
